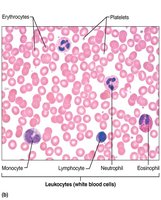
Blood smear showing erythrocytes, leukocytes, and platelets

Back
Backch 17 Blood: Structure, Function, and Hemostasis – Study Notes for ANP College Students
Study Guide - Smart Notes

Blood: Structure, Function, and Hemostasis
Functions of Blood
Blood is a vital connective tissue that performs essential functions for the maintenance of homeostasis in the human body. Its main roles are categorized into transport, regulation, and protection.
Transport:
Delivers oxygen (O2) and nutrients to body cells.
Transports metabolic wastes (e.g., CO2, urea) to lungs and kidneys for elimination.
Carries hormones from endocrine organs to target tissues.
Regulation:
Maintains body temperature by absorbing and distributing heat.
Regulates pH using buffers, including the bicarbonate system.
Maintains fluid volume in the circulatory system.
Protection:
Prevents blood loss via clotting mechanisms (platelets and plasma proteins).
Prevents infection by transporting immune cells (antibodies, complement proteins, white blood cells).
Composition of Blood
Blood is the only fluid tissue in the body and is classified as a connective tissue. It consists of a liquid matrix called plasma and cellular elements known as formed elements.
Plasma: Nonliving fluid matrix, makes up about 55% of blood volume.
Formed Elements: Living blood cells suspended in plasma, including erythrocytes (RBCs), leukocytes (WBCs), and platelets.

Physical Characteristics and Volume
Blood is a sticky, opaque fluid with a metallic taste.
Color varies with oxygen content: scarlet red (high O2), dark red (low O2).
pH: 7.35–7.45.
Accounts for ~8% of body weight.
Average volume: Males 5–6 L, Females 4–5 L.
Blood Plasma
Composition of Plasma
Plasma is a straw-colored, sticky fluid that is about 90% water and contains over 100 dissolved solutes, including nutrients, gases, hormones, wastes, proteins, and inorganic ions.
Constituent | Description and Importance |
|---|---|
Water | 90% of plasma volume; dissolving and suspending medium for solutes of blood; absorbs heat |
Electrolytes | Most abundant solutes by number; help maintain plasma osmotic pressure and normal blood pH |
Plasma proteins | 8% of plasma; include albumin (60%), globulins (36%), and fibrinogen (4%) |
Nonprotein nitrogenous substances | By-products of cellular metabolism (urea, uric acid, creatinine, ammonium salts) |
Nutrients (organic) | Materials absorbed from digestive tract (glucose, amino acids, fatty acids, vitamins, etc.) |
Respiratory gases | O2 and CO2; O2 mostly bound to hemoglobin, CO2 transported as bicarbonate ion or bound to hemoglobin |
Hormones | Steroid and thyroid hormones carried by plasma proteins |


Formed Elements of Blood
Types of Formed Elements
The formed elements include erythrocytes, leukocytes, and platelets. Only leukocytes are complete cells; erythrocytes lack nuclei and organelles, and platelets are cell fragments.
Erythrocytes (RBCs): Transport oxygen and carbon dioxide.
Leukocytes (WBCs): Defense against disease.
Platelets: Cell fragments involved in blood clotting.

Erythrocytes (Red Blood Cells)
Structural Characteristics
Erythrocytes are small, biconcave, anucleate cells specialized for gas transport. Their shape increases surface area for gas exchange and allows flexibility to pass through capillaries.
Biconcave disc shape (7.5 μm diameter, 2.5 μm thick).
Filled with hemoglobin (97% of cell volume, excluding water).
No mitochondria; ATP production is anaerobic.
Contain spectrin protein for flexibility.

Function of Erythrocytes
RBCs are dedicated to respiratory gas transport. Hemoglobin binds reversibly with oxygen, allowing efficient O2 and CO2 transport.
Each hemoglobin molecule can carry four O2 molecules.
Normal hemoglobin values: Males 13–18 g/100 ml; Females 12–16 g/100 ml.
Hemoglobin consists of four polypeptide chains (two alpha, two beta) and four heme groups, each with an iron atom that binds O2.

Production of Erythrocytes (Erythropoiesis)
Erythropoiesis is the process of RBC formation, occurring in red bone marrow. It involves several stages from stem cell to mature erythrocyte.
Hematopoietic stem cell (hemocytoblast) → myeloid stem cell → proerythroblast → erythroblast stages → reticulocyte → erythrocyte.
Reticulocyte count indicates the rate of RBC formation.

Regulation of Erythropoiesis
RBC production is regulated by hormonal controls (mainly erythropoietin, EPO) and dietary requirements (iron, vitamin B12, folic acid).
Erythropoietin (EPO): Hormone produced by kidneys (and liver) in response to hypoxia (low O2 levels).
Testosterone increases EPO production, leading to higher RBC counts in males.
Dietary iron is essential for hemoglobin synthesis; vitamin B12 and folic acid are needed for DNA synthesis in developing cells.

Fate and Destruction of Erythrocytes
RBCs have a lifespan of 100–120 days. Old RBCs are removed by macrophages in the spleen, and their components are recycled.
Iron is stored and reused.
Heme is degraded to bilirubin, excreted in bile, and eventually leaves the body as stercobilin in feces.
Globin is broken down into amino acids.

Erythrocyte Disorders
Anemia: Abnormally low O2-carrying capacity; symptoms include fatigue, pallor, dyspnea, and chills. Causes: blood loss, decreased RBC production, or increased RBC destruction.
Polycythemia: Excess RBCs increase blood viscosity, causing sluggish blood flow. Can be primary (bone marrow cancer) or secondary (high altitude, increased EPO).
Leukocytes (White Blood Cells)
General Structure and Function
Leukocytes are the only complete cells among the formed elements. They defend the body against infection and can leave the bloodstream to enter tissues (diapedesis).
Normal count: 4,800–10,800 WBCs/μl blood.
Leukocytosis: WBC count >11,000/μl, usually in response to infection.
Two main categories: Granulocytes (neutrophils, eosinophils, basophils) and Agranulocytes (lymphocytes, monocytes).


Granulocytes
Neutrophils: Most numerous (50–70%), multilobed nucleus, phagocytic, "bacteria slayers."
Eosinophils: 2–4%, bilobed nucleus, red granules, attack parasitic worms, modulate allergies/asthma.
Basophils: 0.5–1%, large granules with histamine, mediate inflammation, similar to mast cells.



Agranulocytes
Lymphocytes: 25%, large nucleus, crucial for immunity. T cells attack infected/tumor cells; B cells produce antibodies.
Monocytes: 3–8%, largest WBC, U/kidney-shaped nucleus, become macrophages in tissues, phagocytic.


Production and Life Span of Leukocytes (Leukopoiesis)
Leukopoiesis is stimulated by interleukins and colony-stimulating factors (CSFs). All leukocytes originate from hemocytoblasts and differentiate into myeloid or lymphoid lineages.
Granulocytes: Myeloblast → promyelocyte → myelocyte → band cell → mature granulocyte.
Agranulocytes: Monoblast → promonocyte → monocyte; lymphoid stem cells → lymphocytes (T and B cells mature in thymus and bone marrow, respectively).

Platelets
Structure and Function
Platelets are cell fragments derived from megakaryocytes. They play a critical role in hemostasis by forming temporary plugs to seal vessel breaks.
Normal count: 150,000–400,000/μl blood.
Contain chemicals for clotting (serotonin, calcium, enzymes, ADP, PDGF).
Formation regulated by thrombopoietin.

Hemostasis
Overview of Hemostasis
Hemostasis is the process of stopping bleeding through a series of rapid, localized reactions involving platelets and clotting factors.
Step 1: Vascular Spasm – Vasoconstriction of damaged vessel.
Step 2: Platelet Plug Formation – Platelets adhere to exposed collagen, become activated, and aggregate.
Step 3: Coagulation – Fibrin threads reinforce the platelet plug, forming a stable clot.

Coagulation Pathways
Coagulation involves a cascade of reactions leading to the conversion of fibrinogen to fibrin. There are two initial pathways (intrinsic and extrinsic) that converge to a common pathway.
Intrinsic Pathway: Initiated by factors within the blood (e.g., exposed collagen).
Extrinsic Pathway: Triggered by tissue factor (TF) from outside the blood.
Both pathways activate factor X, leading to the formation of prothrombin activator.
Prothrombin activator converts prothrombin to thrombin, which then converts fibrinogen to fibrin.


Clot Retraction and Fibrinolysis
After clot formation, the clot retracts to bring wound edges together and is eventually dissolved by fibrinolysis.
Clot Retraction: Platelet actin and myosin contract, squeezing serum from the clot.
Fibrinolysis: Plasminogen is converted to plasmin, which digests fibrin and dissolves the clot.

Blood Clotting Factors (Procoagulants)
Clotting factors are mostly plasma proteins, numbered I to XIII. Vitamin K is required for the synthesis of several factors.
Factor Number | Factor Name | Source | Primary Function |
|---|---|---|---|
I | Fibrinogen | Liver | Converted to fibrin (insoluble weblike substance of clot) |
II | Prothrombin | Liver | Converted to thrombin (enzyme) |
IV | Calcium ions (Ca2+) | Diet, bones, platelets | Essential for all stages of coagulation |
V | Proaccelerin | Liver, platelets | Common pathway factor |
VIII | Antihemophilic factor (AHF) | Liver, lung, capillaries | Intrinsic pathway factor; deficiency causes hemophilia A |
XIII | Fibrin stabilizing factor (FSF) | Liver, bone marrow | Cross-links fibrin, forming a strong, stable clot |
... | ... | ... | ... |

Blood Transfusions and Replacement
Blood transfusions are used to restore blood volume and oxygen-carrying capacity after significant blood loss. Volume can be temporarily replaced with saline or electrolyte solutions, but only transfused RBCs restore oxygen transport.
Loss of 15–30% of blood volume causes weakness; loss of >30% can be fatal without intervention.
Additional info: This guide covers the essential concepts of blood structure, function, and hemostasis as outlined in Chapter 17 of a standard Human Anatomy & Physiology textbook. It is suitable for ANP college students preparing for exams or seeking a concise review of the topic.
